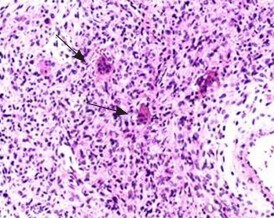

下载或打开 医联APP 查看完整评论
立即下载
打开APP
患者女,46岁,发现右颈肩部包块7年余。右颈肩部触及一包块,渐进性增大,周围无红肿,皮温不高,无明显压痛、叩痛,肩关节活动未见明显受限,右侧颈神经根牵拉试验阴性。
检查:右肩关节CT平扫后行多平面重建:右侧第1肋骨见骨质破坏侵犯T1椎体及横突,病灶呈膨胀性改变,大小约7cm x5cm,密度不均,内见不规则的条片状骨样密度影,骨皮质不连续处可见软组织密度影,周围肌肉软组织及右肺尖呈推压改变。

CT诊断:右侧第1肋骨软骨肉瘤可能性大。 治疗:手术治疗。术中牵开前、中斜角肌后可见一约拳头大小病灶,有完整骨性包膜,向下顶压肺尖,向内连于T1椎体横突,包膜部分破裂后有骨样组织溢出。病理诊断为(肋骨)骨巨细胞瘤。
讨论:骨巨细胞瘤好发于长管骨的骨端突出部位,以股骨下端最为多见。肋骨病变侵犯椎体尤为罕见,诊断困难,主要需要和软骨肉瘤、动脉瘤样骨囊肿相鉴别。DOI:10.3969/j.issn.1005-5185.2015.03.016